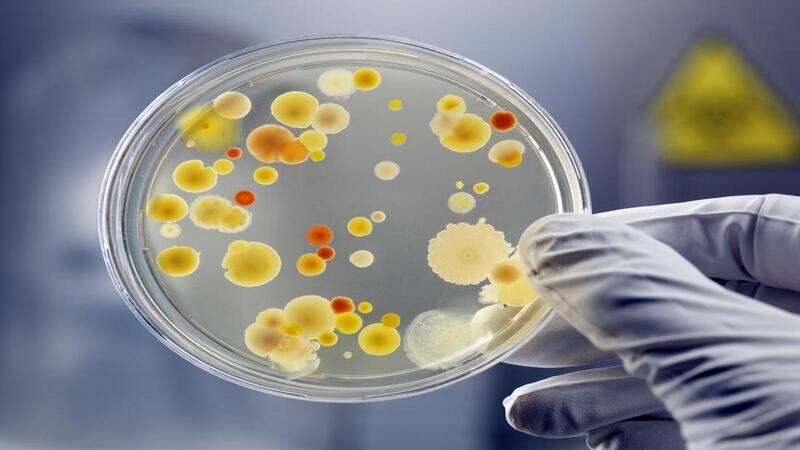
Nuôi cấy vi khuẩn là tiêu chuẩn vàng giúp chẩn đoán bệnh lao

Lao hệ tiết niệu sinh dục phổ biến thứ 3 trong các loại lao ngoài phổi có thể gây vô sinh ở nam và nữ. Cùng tìm hiểu rõ hơn về bệnh lao hệ tiết niệu sinh dục thông qua bài viết dưới đây.
1Lao hệ tiết niệu sinh dục là gì?
Lao hệ tiết niệu sinh dục là dạng lao phổ biến thứ ba trong các bệnh lao ngoài phổi, xếp sau lao hạch và lao màng phổi.
Lao hệ tiết niệu sinh dục thường biểu hiện ở phần đài bể thận, niệu quản, bàng quang và hiếm khi gây ra tình trạng viêm nhiễm áp-xe thận.
Ở nam, lao hệ tiết niệu sinh dục ảnh hưởng trên toàn bộ đường niệu dục từ niệu đạo, tiền liệt tuyến, tinh hoàn và mào tinh.[1]
Ở nữ, lao hệ tiết niệu sinh dục thường ảnh hưởng đến buồng trứng, vòi trứng và ít khi ảnh hưởng đến nội mạc tử cung.[1]

Lao hệ tiết niệu sinh dục phổ biến thứ 3 trong các loại lao ngoài phổi
2Phân loại lao hệ tiết niệu sinh dục
Lao thận
Lao thận là dạng lao hệ tiết niệu sinh dục phổ biến nhất với các triệu chứng thường không điển hình. Điều này gây nhiều khó khăn trong quá trình chẩn đoán nên tổn thương có thể lan rộng đến nhu mô dẫn đến suy thận mạn, tăng huyết áp kháng trị.[1]

Lao thận là dạng lao hệ tiết niệu sinh dục phổ biến nhất
Lao niệu quản
Lao hệ tiết niệu sinh dục thường ảnh hưởng nhiều nhất đến phần dưới của niệu quản, tiếp theo là chỗ nối bể thận niệu quản.
Các triệu chứng thường không đặc hiệu nhưng có thể gây tắc nghẽn và hình thành đoạn hẹp niệu quản, dẫn đến tình trạng thận ứ nước và suy thận sau đó.[1]
Lao bàng quang
Lao bàng quang thường xảy ra khi vi khuẩn gây bệnh lao từ thận xâm nhập xuống gây bệnh tại bàng quang. Ngoài ra, bệnh cũng có thể xảy ra do sự lan truyền từ hệ bạch huyết hoặc lây truyền qua đường máu.[1]
Tương tự như lao niệu quản, lao bàng quang có thể gây viêm kích thích bàng quang biểu hiện bằng triệu chứng tiểu lắt nhắt và/hoặc hình thành chỗ hẹp dẫn đến ứ nước niệu quản và suy thận.
Bệnh nhân có thể có các đặc điểm của nhiễm trùng đường tiết niệu nhưng không đáp ứng với liệu pháp kháng sinh tiêu chuẩn.

Lao bàng quang có thể gây thận ứ nước
Lao tuyến tiền liệt
Lao tuyến tiền liệt thường xảy ra do sự lây lan vi khuẩn lao theo đường máu từ ổ nhiễm lao ban đầu.
Giai đoạn đầu, bệnh nhân có thể không có triệu chứng, sau đó xuất hiện các triệu chứng không đặc hiệu. Ở giai đoạn sau, bệnh nhân có thể có triệu chứng tiểu khó, tiểu đêm hoặc tiểu nhiều lần.
Ngoài ra, người bệnh cũng có thể bị đau vùng chậu cấp tính hoặc mãn tính do viêm tuyến tiền liệt cũng như rối loạn chức năng tình dục.[1]

Người bệnh lao tuyến tiền liệt có thể gặp triệu chứng tiểu khó
Lao dương vật
Lao dương vật có thể biểu hiện dưới dạng một hoặc nhiều vết loét trên dương vật, có thể gây đau hoặc không. Bệnh cũng có thể liên quan đến viêm niệu đạo, hẹp hoặc rò niệu đạo và rối loạn cương dương.[1]
Lao bìu
Viêm mào tinh hoàn do lao có thể biểu hiện dưới dạng tổn thương một hoặc hai bên với tình trạng sưng bìu cấp tính hoặc mãn tính, đau hoặc không đau. Bệnh nhân có thể bị thiểu tinh hoặc vô tinh do sự phá hủy hoặc tắc nghẽn ống dẫn tinh hoặc mào tinh hoàn.[1]
Lao tử cung, buồng trứng, vòi trứng
Các triệu chứng của lao tử cung, buồng trứng, vòi trứng thường không đặc hiệu. Người bệnh có thể gặp tình trạng kinh nguyệt không đều, đau bụng âm ỉ, vô sinh.[1]
3Nguyên nhân gây lao hệ tiết niệu sinh dục
Tương tự như các trường hợp mắc bệnh lao khác, lao hệ tiết niệu sinh dục cũng do vi khuẩn lao Mycobacterium tuberculosis gây ra.[2]
Nguyên nhân gây lao hệ tiết niệu sinh dục là do sự lây lan của vi khuẩn lao theo đường máu từ ổ nhiễm trùng ban đầu đến các cơ quan tiết niệu sinh dục của người bệnh.[2]
Bên cạnh đó, lao hệ tiết niệu sinh dục còn có thể lây lan qua hệ bạch huyết và lây truyền qua đường tình dục.[2] 
Lao hệ tiết niệu sinh dục do vi khuẩn Mycobacterium tuberculosis gây ra
4Yếu tố nguy cơ
Những yếu tố nguy cơ làm tăng khả năng mắc bệnh lao hệ tiết niệu sinh dục được chia làm hai nhóm chính bao gồm:[2]
- Tình trạng suy giảm miễn dịch: Người mắc HIV, tiểu đường, đang dùng thuốc ức chế miễn dịch và có ghép tạng (ghép thận, ghép gan, ghép tim).
- Tiếp xúc môi trường khả năng cao lây nhiễm: Những người lạm dụng thuốc lá, rượu bia, chất kích thích, gầy, suy dinh dưỡng và thiếu vitamin D khi sống trong môi trường tiếp xúc nhiều người nhiễm lao sẽ có khả năng mắc bệnh cao hơn.

Người mắc HIV có khả năng cao mắc lao hệ tiết niệu sinh dục
5Dấu hiệu của bệnh lao hệ tiết niệu sinh dục
Dấu hiệu của bệnh lao hệ tiết niệu sinh dục rất đa dạng, tùy thuộc vào cơ quan bị tổn thương bao gồm:[2]
- Viêm mào tinh hoàn là biểu hiện thường gặp nhất ở nam (dao động từ 10 - 55%). Các triệu chứng khác có thể bao gồm vết loét ở dương vật hoặc khối bất thường ở bìu hoặc mào tinh hoàn ở nam giới.
- Ở nữ biểu hiện kín đáo hơn, có thể là vô sinh (40-75%), đau bụng (50%), rối loạn kinh nguyệt (25%).
- Khi lao hệ tiết niệu sinh dục xảy ra ở thận có thể làm tăng tần suất đi tiểu, tiểu máu và tiểu khó.
- Lao hệ tiết niệu sinh dục khi ảnh hưởng đến niệu quản có thể gây hẹp niệu quản, dẫn đến tổn thương thận do tắc nghẽn.

Đau bụng là triệu chứng thường gặp của lao hệ tiết niệu sinh dục ở nữ
6Biến chứng do lao hệ tiết niệu sinh dục
Lao hệ tiết niệu sinh dục nếu không được chẩn đoán và điều trị kịp thời có thể gây ra nhiều biến chứng nguy hiểm cho người bệnh bao gồm:

Lao hệ tiết niệu sinh dục có thể dẫn đến suy thận mạn
7Chẩn đoán lao hệ tiết niệu sinh dục
Khám lâm sàng
Để góp phần chẩn đoán xác định lao hệ tiết niệu sinh dục, bác sĩ chuyên khoa có thể khai thác một số thông tin sau:
- Triệu chứng bất thường và diễn tiến.
- Tiền sử dùng thuốc và các bệnh lý trước đây.
- Tiền sử gia đình, tiền sử lâm sàng, yếu tố kinh tế xã hội
- Thói quen ăn uống và sinh hoạt.
- Thăm khám thực thể nhằm phát hiện bất thường ở các cơ quan.
Các xét nghiệm cận lâm sàng
- Xét nghiệm máu, PCR nước tiểu
- X-quang, siêu âm, CT và MRI: Giúp hỗ trợ chẩn đoán lao hệ tiết niệu sinh dục trong trường hợp không có chẩn đoán vi sinh cũng như sinh thiết và mô bệnh học.
- Nội soi: Nội soi bàng quang niệu đạo, nội soi niệu quản và nội soi ổ bụng rất hữu ích trong việc lấy mẫu để xét nghiệm vi sinh và mô bệnh học.
Nuôi cấy vi khuẩn là tiêu chuẩn vàng giúp chẩn đoán bệnh lao
8Khi nào cần gặp bác sĩ?
Dấu hiệu cần gặp bác sĩ
Lao hệ tiết niệu sinh dục cần được phát hiện và điều trị sớm nhằm hạn chế những biến chứng nguy hiểm cho người bệnh. Vì vậy, bạn cần đến gặp bác sĩ khi xuất hiện những triệu chứng như:
- Tiểu ra máu.
- Đau bụng không liên quan đến kinh nguyệt ở nữ.
- Vết loét ở dương vật.
- Sờ thấy khối u hoặc sưng bất thường ở bìu hoặc mào tinh ở nam giới.
Nơi thăm khám bệnh và điều trị
Khi thấy xuất hiện các dấu hiệu trên, bạn cần đến cơ sở y tế gần nhất hoặc chuyên khoa lao thuộc các bệnh viện uy tín để được thăm khám và điều trị kịp thời, bạn có thể tham khảo một số bệnh viện uy tín sau:
- TP. Hồ Chí Minh: bệnh viện Phạm Ngọc Thạch, bệnh viện Chợ Rẫy, bệnh viện Đại học Y Dược.
- Hà Nội: bệnh viện phổi Trung ương, bệnh viện Bạch Mai, bệnh viện Đại học Y Hà Nội.
9Điều trị lao hệ tiết niệu sinh dục
Thuốc
Hiện tại lao hệ tiết niệu sinh dục được điều trị giống như lao phổi với phác đồ bốn thuốc bao gồm:[2]
Thời gian điều trị thường kéo dài 6 tháng. Tuy nhiên, một số bệnh nhân có thể cần điều trị lâu hơn bao gồm bệnh nhân đồng nhiễm HIV, áp xe thận hoặc thâm nhiễm xương.
Đối với những bệnh nhân mắc lao đa kháng thuốc thì cần điều trị bằng phác đồ bao gồm các nhóm thuốc như: fluoroquinolones, bedaquiline, delamanid, aminoglycoside và một số thuốc khác. Thời gian điều trị lao đa kháng thuốc có thể kéo dài từ 18 đến 24 tháng.

Rifampicin, isoniazid, pyrazinamide và ethambutol là 4 thuốc điều trị lao hệ tiết niệu sinh dục
Phẫu thuật
Phương pháp phẫu thuật được chỉ định đối với những bệnh nhân mắc lao hệ tiết niệu sinh dục phức tạp với hẹp niệu quản và thận ứ nước nên được điều trị bằng đặt stent sớm hoặc mở thận qua da.
Cắt thận được cân nhắc ở những bệnh nhân có thận không hoạt động, bệnh nhân mắc ung thư biểu mô tế bào thận kèm theo và những người mắc bệnh lan rộng toàn bộ thận.
Hy vọng bài viết đã cung cấp cho bạn những kiến thức liên quan đến bệnh lao hệ tiết niệu. Nếu thấy bài viết hay và hữu ích, hãy chia sẻ cho người thân và bạn bè nhé!
Nguồn tham khảo
Xem thêm 